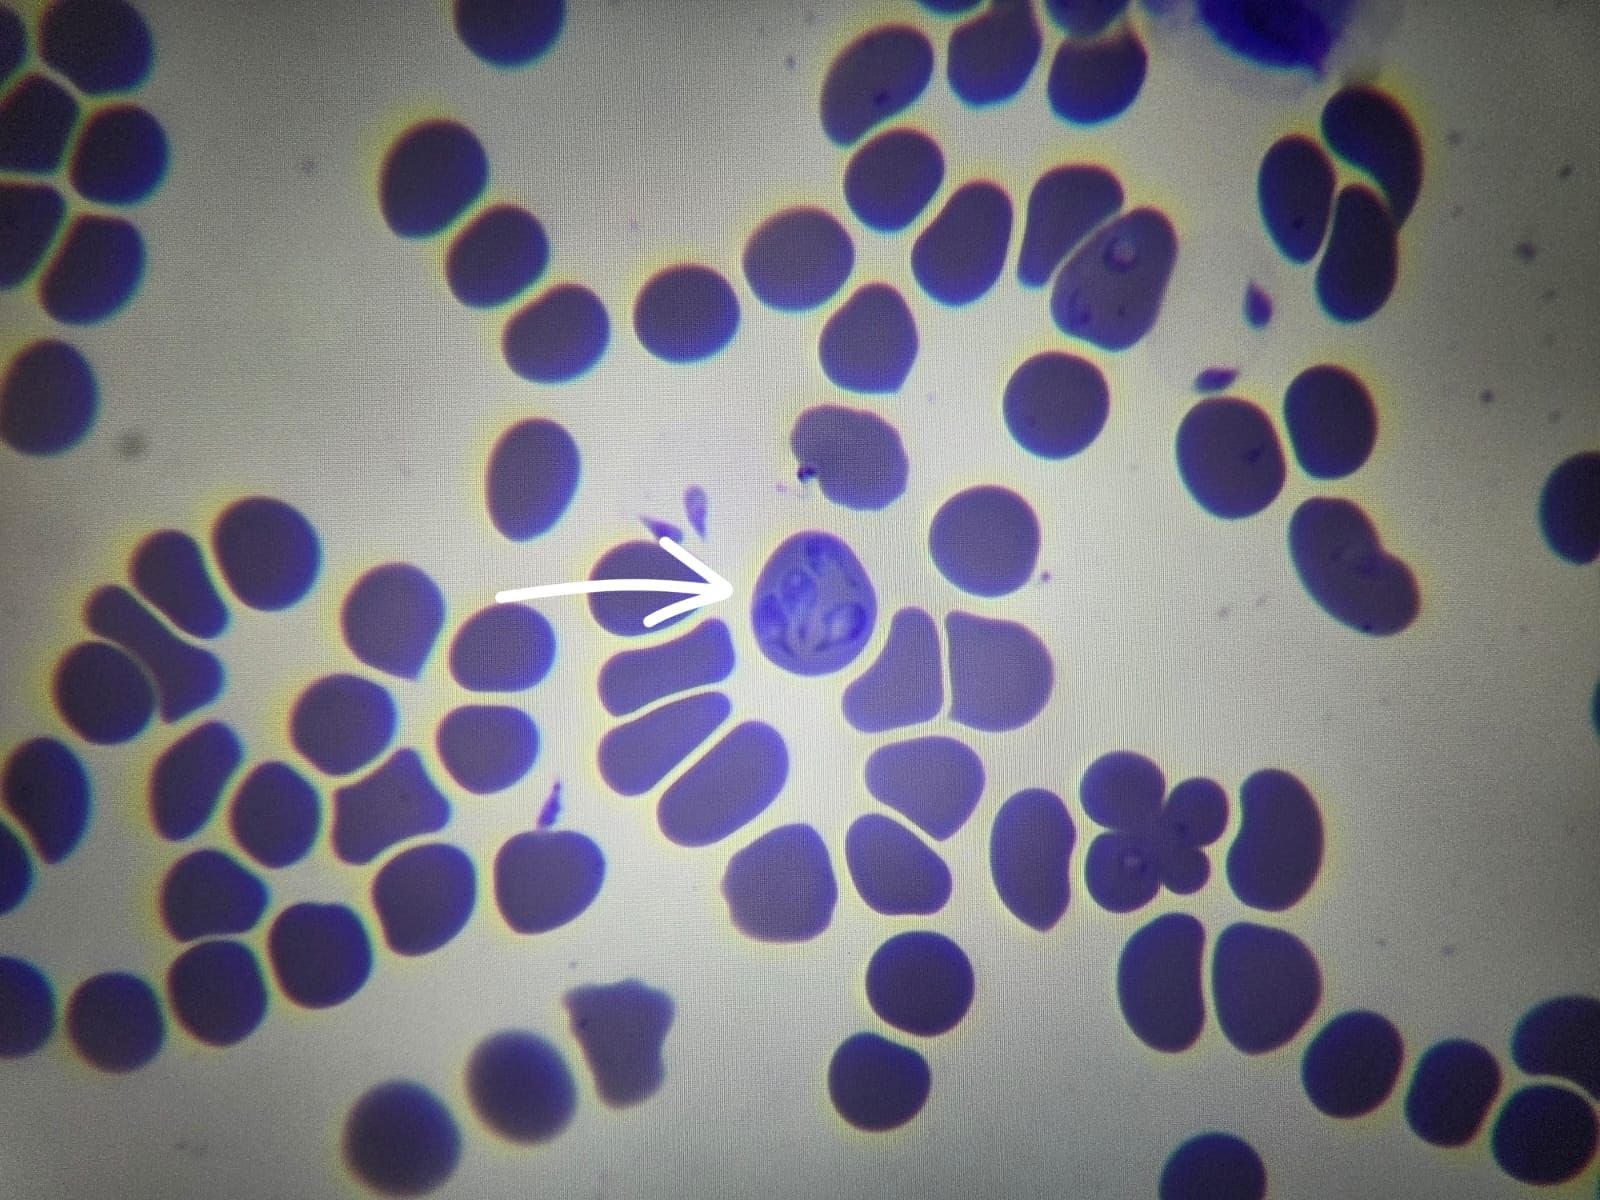

Babesioza - noua boală cu 1000 de fețe
Tradițional, hipoadrenocorticismul canin (Sindromul Addison) era supranumit "Boala cu 1000 de fețe", din cauza prezentărilor foarte variate ale afectiunii.
Insă, odată cu explozia cazurilor de babesioză, această boală concurează acerb pentru titlu.
Ce este babesioza și cum se transmite?
Babesioza este o boală parazitară a sângelui, transmisă de căpușe.
Tabloul clinic clasic este reprezentat de un câine apatic, care urinează închis la culoare, cu febră, eventual icter, cazurile cele mai multe fiind întâlnite primăvara și toamna.
Cazuri atipice: semne care induc în eroare
Și totuși, ce au în comun câinii ale căror imagini le-am selectat?
Niciunul dintre ei nu s-a prezentat clasic.
Motivele pentru care au fost aduși la medic au fost:
Diaree apoasă
Vomă
Probleme cu glandele perianale
Fecale de consistență cretei
Niciunul dintre ei nu prezenta febră, ori alte semne caracteristice de boală.
Lipsa deparazitării externe – un factor comun
Totuși, niciunul dintre acești câini nu fusese deparazitat extern în ultimele luni, astfel încât li s-au recomandat tuturor analize de sânge și examen microscopic al sângelui.
Astfel s-a pus diagnosticul corect și s-a putut institui tratamentul specific.
Deparazitarea externă – esențială în orice anotimp
Pe această cale, dorim să reiterăm importanța deparazitării externe corespunzătoare și regulate a câinilor – indiferent de mediul în care trăiesc.
Odată cu schimbările climatice, cazurile de babesioză au început să apară în orice perioadă a anului.
Căpușele nu țin cont de calendar, iar în lunile de iarnă au început să apară aproape la fel de multe cazuri ca în cele de primăvară, fapt influențat și de concepția tradițională că "E iarnă, nu are nevoie de deparazitare, nu sunt căpușe".
De ce este vitală prezentarea rapidă la medic?
Foarte importantă este și prezentarea la medic, la primele semne de boală.
Babesioza este o boală gravă, care afectează multiple sisteme de organe și poate fi fatală, chiar și cu tratament corespunzător și timpuriu.
Complicațiile grave ale babesiozei
Din păcate, nu toți pacienții pot învinge boala, afectarea renală și anemia severă fiind cele mai frecvente complicații grave.
Adesea, sunt necesare multiple zile de internare, iar cazurile complicate pot necesita îngrijiri suplimentare (hemodializă, hemotransfuzie etc).
Un factor important în reușita tratamentului îl reprezintă și timpul scurs până la prezentarea la medic.
Cu cât intervenim mai repede, cu atât cresc șansele de reușită.
Din păcate, chiar și cu toate îngrijirile, nu toți pacienții pot învinge boala, așa că scopul este să o prevenim, nu să o tratăm.
Prevenția rămâne cea mai bună protecție
Mai mult decât atât, babesioza nu este singura boală transmisă de paraziții externi.
Atât căpușele, cât și puricii și chiar țânțarii, transmit boli grave blănoșilor, iar cea mai bună armă o reprezintă prevenția.
Medicul veterinar poate concepe scheme de deparazitare externă, adaptate fiecărui pacient, pentru a reduce cât mai mult riscul de apariție al acestor afecțiuni grave.
Programează o vizită la Sky Vet și oferă-i companionului tău protecția de care are nevoie, indiferent de sezon!